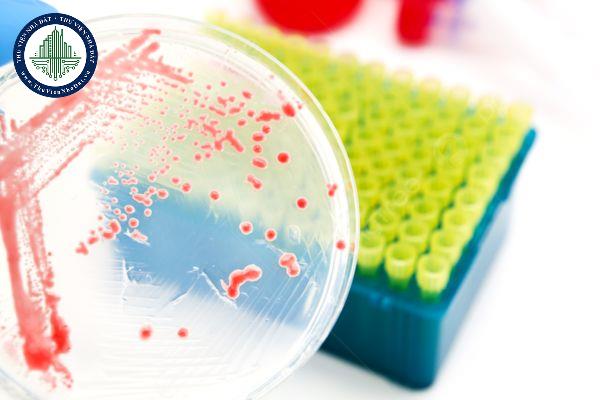
thuviennhadat.vn

Sinh vật biến đổi gen
Sản xuất, kinh doanh sinh vật, sản phẩm sinh vật biến đổi gen khi không có giấy chứng nhận an toàn sinh học sẽ bị phạt đến 100 triệu?
16/04/2025 12:32
Sản xuất, kinh doanh sinh vật, sản phẩm sinh vật biến đổi gen khi không có giấy chứng nhận an toàn sinh học sẽ bị phạt đến 100 triệu?
Ghi nhãn đối với hàng hóa chứa sinh vật biến đổi gen, sản phẩm của sinh vật biến đổi gen được quy định như thế nào?
22/10/2024 14:52
Tôi đang tìm hiểu về vấn đề này và có thắc mắc sau. Ghi nhãn đối với hàng hóa chứa sinh vật biến đổi gen, sản phẩm của sinh vật biến đổi gen được quy định như thế nào?
Lưu giữ, đóng gói, vận chuyển sinh vật biến đổi gen, sản phẩm của sinh vật biến đổi gen được quy định như thế nào?
22/10/2024 14:45
Tôi đang tìm hiểu về vấn đề này và có thắc mắc sau. Lưu giữ, đóng gói, vận chuyển sinh vật biến đổi gen, sản phẩm của sinh vật biến đổi gen được quy định như thế nào?
Quy định về điều kiện sản xuất kinh doanh sinh vật biến đổi gen, sản phẩm sử dụng làm thức ăn chăn nuôi là gì?
22/10/2024 14:23
Tôi đang tìm hiểu về vấn đề này và có thắc mắc sau. Quy định về điều kiện sản xuất kinh doanh sinh vật biến đổi gen, sản phẩm sử dụng làm thức ăn chăn nuôi là gì?
Quy định về điều kiện sản xuất kinh doanh sinh vật biến đổi gen, sản phẩm của sinh vật biến đổi gen sử dụng làm thực phẩm
22/10/2024 14:20
Tôi đang tìm hiểu về vấn đề này và có thắc mắc sau. Quy định về điều kiện sản xuất kinh doanh sinh vật biến đổi gen, sản phẩm của sinh vật biến đổi gen sử dụng làm thực phẩm.
Nội dung giấy xác nhận sinh vật biến đổi gen đủ điều kiện sử dụng làm thức ăn chăn nuôi được quy định như thế nào?
22/10/2024 14:02
Tôi đang tìm hiểu về vấn đề này và có thắc mắc sau. Nội dung giấy xác nhận sinh vật biến đổi gen đủ điều kiện sử dụng làm thức ăn chăn nuôi được quy định như thế nào?
Quy định về danh mục sinh vật biến đổi gen được cấp giấy xác nhận đủ điều kiện sử dụng làm thực phẩm là gì?
22/10/2024 13:57
Tôi đang tìm hiểu về vấn đề này và có thắc mắc sau. Quy định về danh mục sinh vật biến đổi gen được cấp giấy xác nhận đủ điều kiện sử dụng làm thực phẩm là gì?
Nội dung giấy xác nhận sinh vật biến đổi gen đủ điều kiện sử dụng làm thực phẩm được quy định như thế nào?
22/10/2024 13:51
Tôi đang tìm hiểu về vấn đề này và có thắc mắc sau. Nội dung giấy xác nhận sinh vật biến đổi gen đủ điều kiện sử dụng làm thực phẩm được quy định như thế nào?
Thu hồi giấy xác nhận sinh vật biến đổi gen đủ điều kiện sử dụng làm thực phẩm được quy định như thế nào?
22/10/2024 13:49
Tôi đang tìm hiểu về vấn đề này và có thắc mắc sau. Thu hồi giấy xác nhận sinh vật biến đổi gen đủ điều kiện sử dụng làm thực phẩm được quy định như thế nào?
Điều kiện cấp Giấy xác nhận sinh vật biến đổi gen đủ điều kiện sử dụng làm thực phẩm được quy định như thế nào?
22/10/2024 13:45
Tôi đang tìm hiểu về vấn đề này và có thắc mắc sau. Điều kiện cấp Giấy xác nhận sinh vật biến đổi gen đủ điều kiện sử dụng làm thực phẩm được quy định như thế nào?
Quy định về danh mục sinh vật biến đổi gen được cấp giấy chứng nhận an toàn sinh học là gì?
22/10/2024 13:43
Tôi đang tìm hiểu về vấn đề này và có thắc mắc sau. Quy định về danh mục sinh vật biến đổi gen được cấp giấy chứng nhận an toàn sinh học là gì? Văn bản nào nói về điều này?
Theo quy định của pháp luật Việt Nam, trách nhiệm thực hiện khảo nghiệm sinh vật biến đổi gen là gì?
22/10/2024 11:04
Tôi đang tìm hiểu về vấn đề này và có thắc mắc sau. Theo quy định của pháp luật Việt Nam, trách nhiệm thực hiện khảo nghiệm sinh vật biến đổi gen là gì?
Theo quy định của pháp luật Việt Nam, nội dung giấy phép khảo nghiệm sinh vật biến đổi gen là gì?
22/10/2024 11:01
Tôi đang tìm hiểu về vấn đề này và có thắc mắc sau. Theo quy định của pháp luật Việt Nam, nội dung giấy phép khảo nghiệm sinh vật biến đổi gen là gì?
Theo quy định của pháp luật Việt Nam, điều kiện công nhận Cơ sở khảo nghiệm sinh vật biến đổi gen là gì?
22/10/2024 10:58
Tôi đang tìm hiểu về vấn đề này và có thắc mắc sau. Theo quy định của pháp luật Việt Nam, điều kiện công nhận Cơ sở khảo nghiệm sinh vật biến đổi gen là gì?
Đối với hoạt động nghiên cứu khoa học, phát triển công nghệ, sản phẩm về sinh vật biến đổi gen cần có yêu cầu gì?
22/10/2024 10:57
Tôi đang tìm hiểu về vấn đề này và có thắc mắc sau. Đối với hoạt động nghiên cứu khoa học, phát triển công nghệ, sản phẩm về sinh vật biến đổi gen cần có yêu cầu gì?
Điều kiện đối với phòng thí nghiệm nghiên cứu về sinh vật biến đổi gen được quy định thế nào?
22/10/2024 10:56
Tôi đang tìm hiểu về vấn đề này và có thắc mắc sau. Điều kiện đối với phòng thí nghiệm nghiên cứu về sinh vật biến đổi gen được quy định thế nào? Văn bản nào nói về điều này?
Quy định về thanh tra, kiểm tra việc thực hiện các biện pháp quản lý rủi ro của sinh vật biến đổi gen là gì?
22/10/2024 10:31
Tôi đang tìm hiểu về vấn đề này và có thắc mắc sau. Quy định về thanh tra, kiểm tra việc thực hiện các biện pháp quản lý rủi ro của sinh vật biến đổi gen là gì?
Đối với môi trường, đa dạng sinh học, sức khỏe và vật nuôi, trách nhiệm quản lý rủi ro của sinh vật biến đổi gen là gì?
22/10/2024 10:28
Tôi đang tìm hiểu về vấn đề này và có thắc mắc sau. Đối với môi trường, đa dạng sinh học, sức khỏe và vật nuôi, trách nhiệm quản lý rủi ro của sinh vật biến đổi gen là gì?
Quy định về báo cáo đánh giá rủi ro của sinh vật biến đổi gen đối với môi trường, đa dạng sinh học, sức khỏe và vật nuôi
22/10/2024 10:25
Tôi đang tìm hiểu về vấn đề này và có thắc mắc sau. Quy định về báo cáo đánh giá rủi ro của sinh vật biến đổi gen đối với môi trường, đa dạng sinh học, sức khỏe và vật nuôi.
Đối với môi trường, đa dạng sinh học và vật nuôi, nội dung đánh giá rủi ro của sinh vật biến đổi gen là gì?
22/10/2024 10:16
Tôi đang tìm hiểu về vấn đề này và có thắc mắc sau. Đối với môi trường, đa dạng sinh học và vật nuôi, nội dung đánh giá rủi ro của sinh vật biến đổi gen là gì?



















.jpg)

.jpg)
.jpg)

.jpg)
.jpg)
.jpg)

.jpg)